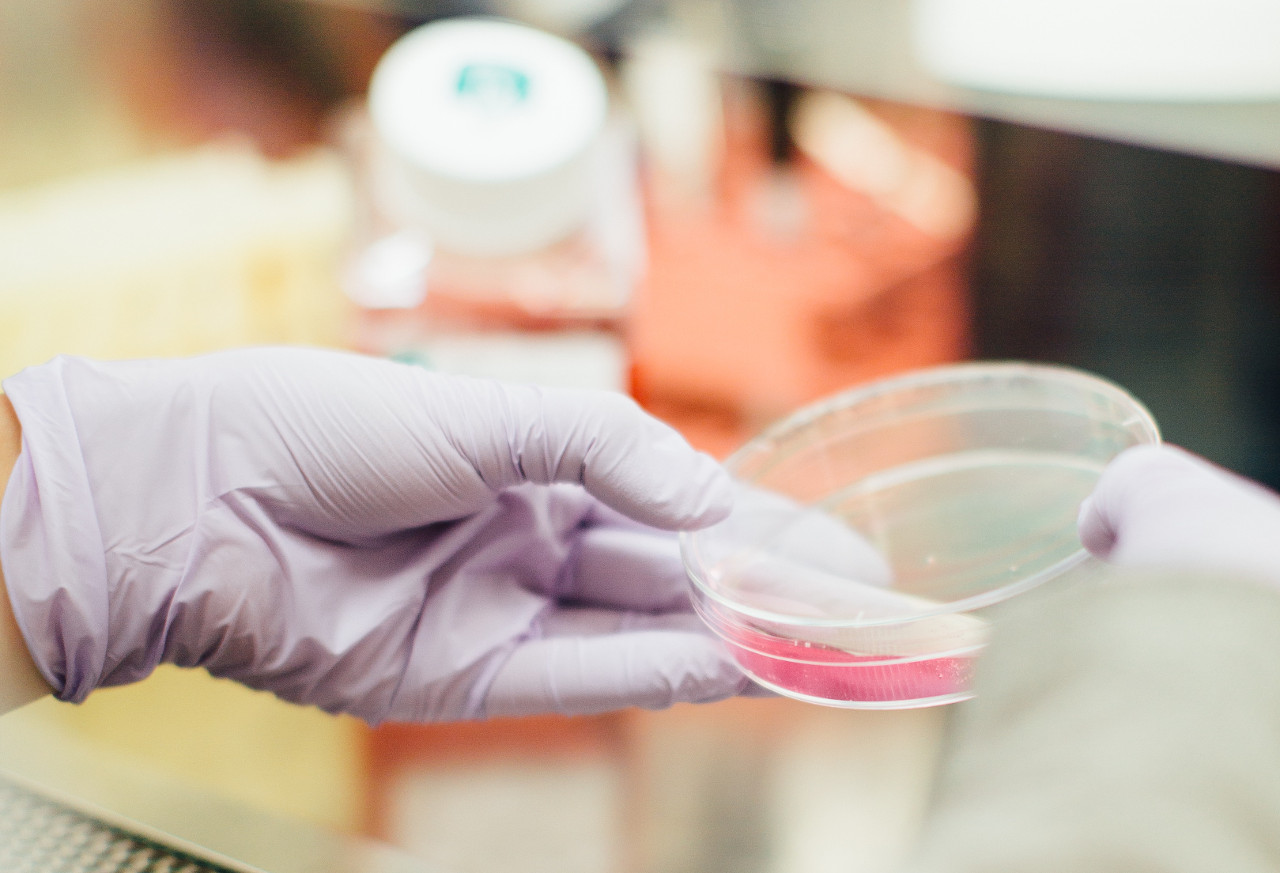

Número 4 Nueva Época - 2019-02-24
 EDITORIALPor Occam's RazorPor fin el número 4 de Occam's Razor está listo. De nuevo, este número solo estará disponible en formato web (tampoco nadie nos ha pedido el PDF del número anterior :).
EDITORIALPor Occam's RazorPor fin el número 4 de Occam's Razor está listo. De nuevo, este número solo estará disponible en formato web (tampoco nadie nos ha pedido el PDF del número anterior :). GNU-LINUXPor Nelly KerninghamEn este artículo os vamos a contar todos los secretos para trabajar con imágenes de disco en plan profesional. Si bien existen muy buenas herramientas hoy en día que nos permiten hacer prácticamente de todo, nosotros que somos mú tradicionales vamos a contaros como trabajar con imágenes de disco en la línea de comandos. Amo allá.
GNU-LINUXPor Nelly KerninghamEn este artículo os vamos a contar todos los secretos para trabajar con imágenes de disco en plan profesional. Si bien existen muy buenas herramientas hoy en día que nos permiten hacer prácticamente de todo, nosotros que somos mú tradicionales vamos a contaros como trabajar con imágenes de disco en la línea de comandos. Amo allá.
 SEGURIDADPor Andrés "Andy" Pajaquer Si no eres un Rock Star de la seguridad informático y Cyber te sugiere una sidra fresquita, entonces, debes de andar acojonado. Todo el mundo se esfuerza por asustar a la población con historias de miedo, muchas de ellas bastante fantásticas. Mú triste. Bueno, pues si no eres más que un mero mortal y quieres enterarte de que es eso de los CyberLoQueSea, sigue leyendo.
SEGURIDADPor Andrés "Andy" Pajaquer Si no eres un Rock Star de la seguridad informático y Cyber te sugiere una sidra fresquita, entonces, debes de andar acojonado. Todo el mundo se esfuerza por asustar a la población con historias de miedo, muchas de ellas bastante fantásticas. Mú triste. Bueno, pues si no eres más que un mero mortal y quieres enterarte de que es eso de los CyberLoQueSea, sigue leyendo. SEGURIDADPor Don Bit0A parte de saber que los virus informáticos hacen que nuestro ordenador se ponga malito, sabéis algo más sobre estos intrigantes bichillos?. La mejor forma de estar protegidos ante esta amenaza, es como diría Zum Zum, conocer a tu enemigo.
SEGURIDADPor Don Bit0A parte de saber que los virus informáticos hacen que nuestro ordenador se ponga malito, sabéis algo más sobre estos intrigantes bichillos?. La mejor forma de estar protegidos ante esta amenaza, es como diría Zum Zum, conocer a tu enemigo. SEGURIDADPor Don Bit0
SEGURIDADPor Don Bit0En esta nueva entrega de Seguridad para Meros Mortales, vamos a profundizar en el tema de los exploits. Veremos con ejemplos sencillos las diferencias entre BUGs, Vulnerabilidades y Exploits y esperamos que con ello todos sepamos un poco más sobre los entresijos de la seguridad informática en el siglo XXI :).
 RATASPor Nelly KerninghamUna función hash nos permite calcular una firma asociada a un conjunto de datos. La peculiaridad de estas funciones es que, simplemente modificando un byte de los datos originales, el resultado de la función cambia radicalmente. En este artículo vamos a explicaros como poder calcular cualquier tipo de hash en vuestros programas.
RATASPor Nelly KerninghamUna función hash nos permite calcular una firma asociada a un conjunto de datos. La peculiaridad de estas funciones es que, simplemente modificando un byte de los datos originales, el resultado de la función cambia radicalmente. En este artículo vamos a explicaros como poder calcular cualquier tipo de hash en vuestros programas. DIVULGACIONPor Signul FloidEn los últimos años se ha hablado mucho de estas no tan nuevas tecnologías y, seamos realistas, lejos de dar una idea clara de en que consisten, la han liado parda y el lío mental que tiene la gente es descomunal. En nuestro afán didáctico, vamos a explicaros de una forma fácil y sencilla en que consiste todo esto.
DIVULGACIONPor Signul FloidEn los últimos años se ha hablado mucho de estas no tan nuevas tecnologías y, seamos realistas, lejos de dar una idea clara de en que consisten, la han liado parda y el lío mental que tiene la gente es descomunal. En nuestro afán didáctico, vamos a explicaros de una forma fácil y sencilla en que consiste todo esto. TRUCOSPor Tamariz el de la PerdizUna vez más aquí os traemos la sección con los mejores trucos para vuestros sistemas GNU/Linux. Los secretos de los hackers al alcance de todos!
TRUCOSPor Tamariz el de la PerdizUna vez más aquí os traemos la sección con los mejores trucos para vuestros sistemas GNU/Linux. Los secretos de los hackers al alcance de todos!
